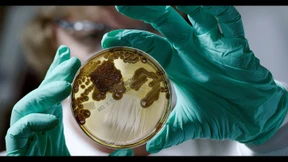
Erfolg für Hochschul-Forscher im Kampf gegen Problemkeime
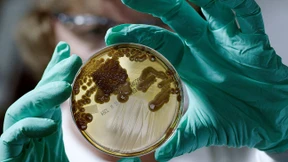
Resistent gegen alles

Ärzte verordnen zu viele „Notnagel-Antibiotika“
Die Resistenzen von Bakterien gegen antibiotische Mittel nehmen zu. Das Wissenschaftliche Institut der AOK warnt, dass die Pharmaindustrie zu wenige neue Wirkstoffe entwickle.

Die Resistenzen von Bakterien gegen antibiotische Mittel nehmen zu. Das Wissenschaftliche Institut der AOK warnt, dass die Pharmaindustrie zu wenige neue Wirkstoffe entwickle.

Die Novartis-Tochtergesellschaft Sandoz will den österreichischen Produktionsstandort für Penicillin nun doch erhalten. In den nächsten fünf Jahren sollen 150 Millionen Euro investiert werden.

Ein neuartiges Patientenzimmer soll das Risiko senken, dass man sich im Krankenhaus eine lebensbedrohliche Infektion holt. Ob das wirklich funktioniert, ist aber noch nicht bewiesen.

Schon vor Corona gab es ständig Lieferengpässe bei Arzneimitteln. Die Gründe liegen im Ausland. Doch der Aufbau einer heimischen Produktion dürfte schwierig werden.

Im Zuge des Coronavirus entspannt sich der Handelsstreit zwischen China und Amerika. Peking streicht Strafzölle auf hunderte Produkte, auch Antibiotika. Die Vereinbarung ist aber zeitlich begrenzt.

Nicht nur neue Mittel, auch neue Strategien werden gebraucht, um resistente Keime auszutricksen. Kieler Forscher testen evolutionäre Konzepte im Labor.
Forscher aus mehreren Ländern, darunter Wissenschaftler der Justus-Liebig-Universität Gießen, melden einen Erfolg auf der Suche nach neuen Wirkstoffen gegen Problemkeime. Die Rede ist von einem neuartigen Antibiotikum.

Bayern lässt Homöopathie als Ersatz für Antibiotikum untersuchen und verwundert damit nicht nur Ärzte. Der Umgang ist besorgniserregend.

Können Globuli eines Tages Antibiotika ersetzen? Der bayerische Landtag verlangt eine Studie. Das erzürnt Homöopathie-Gegner.

Die Biotechgesellschaft Aicuris entwickelt Arzneien gegen Krankheiten, für die es oft noch keine Medikamente gibt. Für die Heilung von Hepatitis B fehlt allerdings noch ein Partner.

An einer Sepsis sterben jedes Jahr zehntausende Menschen. Fachleute kritisieren, dass es in Deutschland noch keine nationale Strategie gibt, um mehr Menschen retten zu können.

Obwohl die Ausbreitung resistenter Keime als eine der größten globalen Gefahren gesehen wird, stoppen Pharmaunternehmen die Forschung an neuen Antibiotika – das könnte gesundheitliche Folgen haben.

Besonders für Babys verschreiben Ärzte immer seltener Bakterienkiller. Ein sparsamer Einsatz soll dafür sorgen, dass die Lebensretter ihre Wirksamkeit behalten. Doch die politisch verordnete Bremse macht sich je nach Region unterschiedlich bemerkbar.

In einer tropischen Riesenzecke, die einen Pferdehalter aus dem Raum Siegen gestochen hat, ist ein Fleckfieber-Erreger nachgewiesen worden. Der Mann konnte erfolgreich mit Antibiotika behandelt werden.

Ob Abspeckkur oder chronische Darmkrankheit – eine Stuhltransplantation soll neuerdings als Allheilmittel helfen. Aber die Therapie zeigt bisher nur bei einem Leiden klare Erfolge.

Wenig Platz und mit Antibiotika vollgepumpt: Dieses Schicksal teilen viele Nutztiere. Besonders in der Geflügelwirtschaft setzen Bauern viele Medikamente ein. Landeswirtschaftsministerin Julia Klöckner will das ändern.

Mit Hilfe von Algorithmen Antibiotikaresistenzen vorhersagen und Augenkrankheiten früh erkennen: Österreich steht gut da, wenn es darum geht mit Hilfe von Künstlicher Intelligenz die Gesundheit zu verbessern.
Der massive Einsatz von Antibiotika in der Tierzucht hat fatale Konsequenzen. Wie Bakterien, die gegen alle bekannten Präparate gefeit sind, sich weltweit ausbreiten, zeigt Michael Wech bei Arte. Das ist der reinste Horrorfilm.

Der massenhafte Einsatz von Antibiotika macht gefährliche Erreger oft resistent. Die Forschung hat nun herausgefunden, wie das geschieht.

Lange Zeit dümpelte der CO2-Preis im Keller herum, jetzt ist er deutlich gestiegen. Das ist gut für die Umwelt. Doch deutsche Unternehmen sind im Klimaschutz schlechter als andere.

Resistente Keime lassen Antibiotika nicht mehr wirken. Eine Lösung sind Neuzulassungen. Doch davon gab es in den vergangenen Jahren nur wenige. Unsere Grafik zeigt warum.

Markus Graf Matuschka von Greiffenclau stammt aus einem alten Adelsgeschlecht. Heute investiert er in Designerproteine – um so das Versagen von Antibiotika zu stoppen.

Das könnte die Lösung der Arzneimittelkrise sein: Kombinationstherapien für alles und jeden. Was in der Krebsmedizin funktioniert, soll auch Antibiotika reanimieren.

Ein neuer Feind macht sich breit in den Kindermündern: Bröckelnde Zähne erschrecken Eltern und lassen Zahnmediziner rätseln. Jetzt wird nach den Ursachen gesucht.

Ein Zeckenstich kann schwere Folgen haben. Denn die Plagegeister können Borrelien übertragen, die Organe und das Gehirn schädigen. Oft hilft eine Antibiotikatherapie – vorausgesetzt, die Diagnose wird früh gestellt.

Gerade jetzt, wenn es langsam wärmer wird, trifft es viele Menschen: Wer eine Erkältung oder die Grippe nicht richtig auskuriert, dem droht eine Lungenentzündung. Was aber passiert dabei eigentlich genau?

Bakterien werden immer öfter resistent gegen Antibiotika, weshalb verstärkt Reservewirkstoffe eingesetzt werden. Was wiederum zu mehr Resistenzen führt. Ein gefährlicher Kreislauf, wie Forscher mit einer neuen Auswertung belegen.

Ob Fluss, Bach oder Teich: Kein Frankfurter Gewässer bietet sich zum Baden an. Überall tummeln sich gegen Antibiotika unempfindliche Krankheitserreger.

Es gibt Hoffnung für Patienten, bei denen Antibiotika nicht mehr wirken: Das Start-up Lysando erzielt große Erfolge mit Artilysinen. Doch nun stößt es an die Grenzen der Pharmaindustrie.

Immer wieder sterben Kinder an Infektionen mit Meningokokken B – kürzlich erst in Südhessen. Durch eine Impfung könnte man sie schützen. Warum impft man nicht alle?

Antibiotika sollen jährlich Millionen Leben retten. Doch weil Ärzte, Patienten und Landwirte fahrlässig damit umgehen, verlieren sie an Wirkung. Lässt sich der Kampf gegen resistente Erreger noch gewinnen?

Wenn der Rücken schmerzt oder das Knie zwickt, verabreichen Ärzte gern Kortison. Auch die Patienten glauben, das hilft. Doch oft stimmt das nicht, und es kann sogar ziemlich ernste Folgen haben.

Pharma war raus. Jetzt verlangt die Branche vom Staat „Anreize“, neue Antibiotika zu entwickeln. Der Fall zeigt: Geschäfte mit der Gesundheit lohnen sich nicht immer. Das Marktversagen kostet weltweit Hunderttausende das Leben. Und es werden immer mehr.

Viele Menschen sterben, weil immer mehr Bakterien gegen Antibiotika immun sind. Kanzlerin Merkel setzt das Thema beim G-20-Treffen hoch auf die Agenda.

Antibiotika gegen leichte Erkältungen, mangelnde Hygiene, Versorgungsengpässe: Gründe für das Versagen der lebensrettenden Arzneien gibt es viele - auch Mittel dagegen?

Was hilft, wenn Antibiotika nicht mehr helfen? Kann es sein, dass man in einem fast vergessenen Forschungsinstitut in Tiflis die beste Antwort darauf hat? Eine Reise nach Georgien – und in eine andere Zeit.